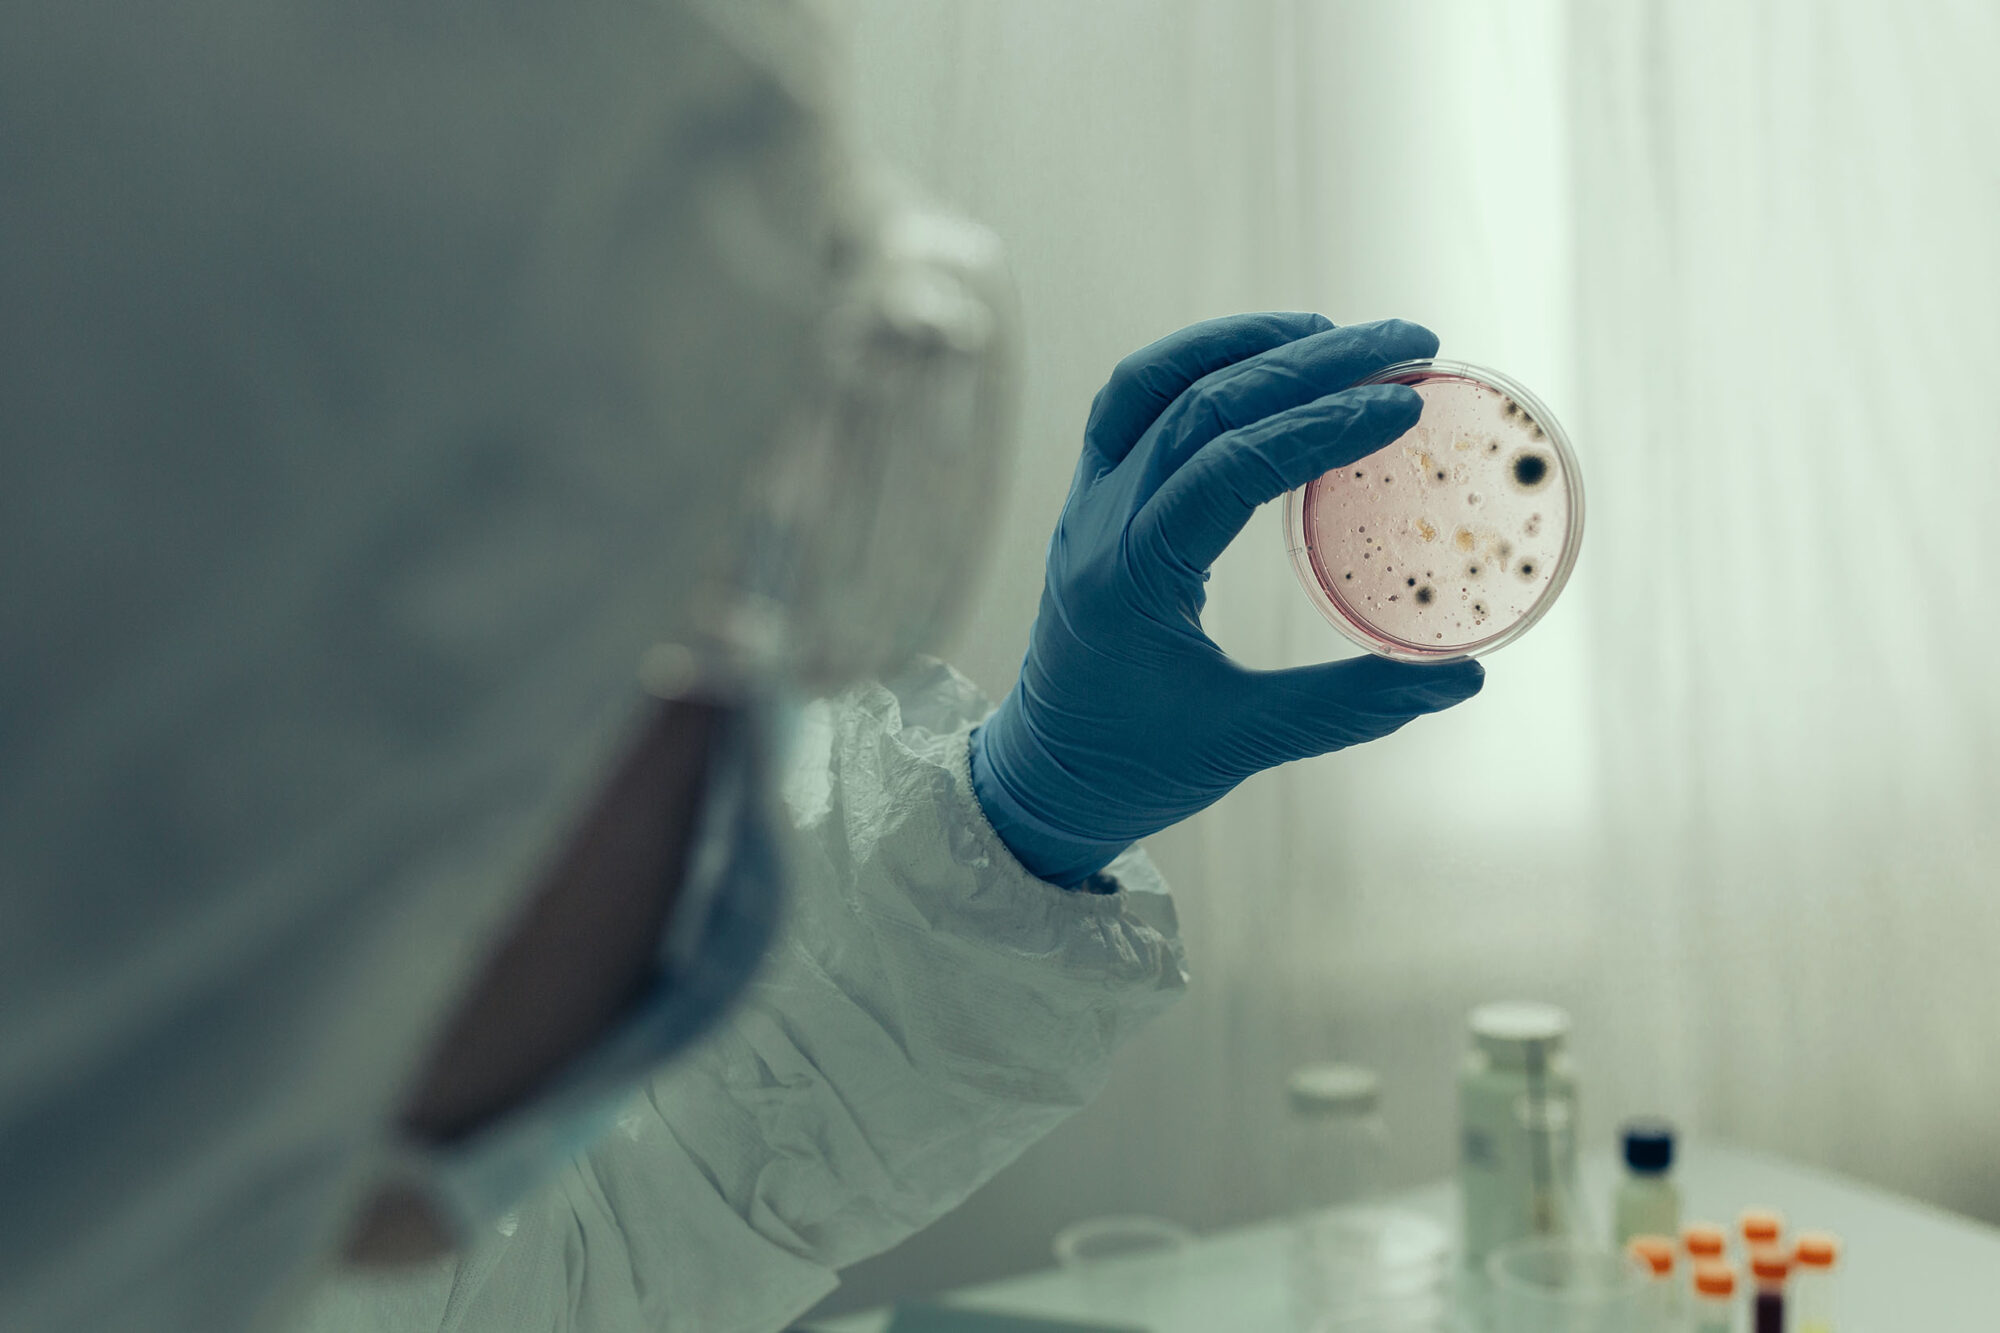
Una infectóloga dijo que “más del 80% de los internados son gente no vacunada”

Biss: “Las personas internadas con coronavirus, por lo general no están vacunadas”
El intendente de Rawson, Damián Biss, habló sobre la situación epidemiológica de la ciudad capital, y aseguró que “nos reunimos con el Comité de Emergencia para analizar la situación por… Leer más about Biss: “Las personas internadas con coronavirus, por lo general no están vacunadas”